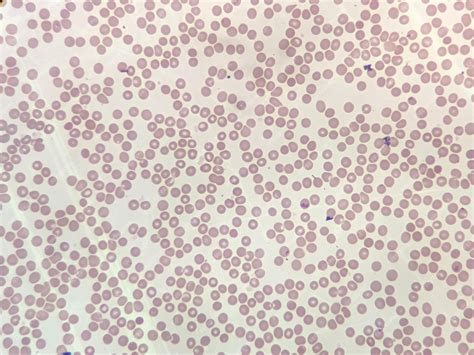
Microscopía de eritrocitos en agua destilada

Los eritrocitos, también conocidos como glóbulos rojos, son las células sanguíneas más abundantes en el cuerpo humano, desempeñando un papel crucial en el transporte de oxígeno y dióxido de carbono. Su estructura y comportamiento ante diferentes medios son de gran interés en diversas áreas de la biología y la medicina. Uno de los fenómenos más estudiados y fundamentales relacionados con los eritrocitos es su comportamiento en agua destilada, un escenario que pone de manifiesto los principios básicos de la ósmosis y la integridad celular. La ruptura de los eritrocitos en agua destilada, conocida como hemólisis, es un proceso que ilustra la delicada relación entre el interior de la célula y su entorno acuoso.
La Naturaleza de los Eritrocitos: Estructura y Función
Los eritrocitos son células anucleares con una forma característica de disco bicóncavo. Este diseño les otorga una gran superficie en relación con su volumen, optimizando el intercambio gaseoso. Su diámetro medio es de aproximadamente 7.8 micras y su espesor varía desde 2.5 mm en los bordes hasta ser más delgado en el centro. La membrana eritrocitaria es excepcionalmente flexible, permitiendo que estas células se deformen y atraviesen capilares de diámetro significativamente menor que el suyo.
La función principal de los eritrocitos es el transporte de hemoglobina, la proteína encargada de captar oxígeno en los pulmones y liberarlo en los tejidos. La hemoglobina también actúa como un excelente amortiguador ácido-base. Otra función vital es la producción de anhidrasa carbónica, una enzima que facilita el transporte de dióxido de carbono (CO2) en forma de bicarbonato (HCO3-) hacia los pulmones para su expulsión.
La producción de eritrocitos, o eritropoyesis, tiene un origen embrionario en el saco vitelino, hígado y bazo, para luego establecerse predominantemente en la médula ósea a partir del último mes de gestación y durante toda la vida. Con la edad, la médula ósea roja se va transformando en médula parda (grasa), disminuyendo la tasa de producción eritrocitaria, aunque esta se mantiene en las porciones proximales de los huesos largos y huesos membranosos.
El Principio Fundamental: La Ósmosis y la Tonicidad
Para comprender la ruptura de los eritrocitos en agua destilada, es esencial entender los conceptos de ósmosis y tonicidad. La ósmosis es el movimiento neto de moléculas de agua a través de una membrana semipermeable, desde una región de menor concentración de solutos hacia una región de mayor concentración de solutos. Este movimiento busca igualar las concentraciones de solutos a ambos lados de la membrana.
La tonicidad, por su parte, se refiere a la concentración efectiva de solutos impermeables a la membrana celular que determina la dirección y la magnitud del flujo osmótico. Las soluciones se clasifican en tres tipos según su tonicidad en relación con el interior de una célula:
- Solución Isotónica: La concentración de solutos es igual dentro y fuera de la célula. No hay movimiento neto de agua, y la célula mantiene su tamaño y forma.
- Solución Hipotónica: La concentración de solutos es menor fuera de la célula que en su interior. El agua tiende a entrar en la célula.
- Solución Hipertónica: La concentración de solutos es mayor fuera de la célula que en su interior. El agua tiende a salir de la célula.

Eritrocitos en Agua Destilada: Un Escenario Hipotónico Extremo
El agua destilada es, por definición, agua pura sin solutos disueltos. Cuando los eritrocitos se colocan en agua destilada, se encuentran en un medio extremadamente hipotónico. La concentración de solutos dentro del eritrocito (iones, proteínas, etc.) es significativamente mayor que en el agua destilada circundante.
Debido a este gradiente de concentración, las moléculas de agua comienzan a difundirse masivamente hacia el interior de los eritrocitos a través de su membrana semipermeable. Este influxo de agua provoca un aumento progresivo del volumen celular. La membrana eritrocitaria, aunque flexible, tiene un límite de elasticidad. Al hincharse la célula más allá de su capacidad, la tensión sobre la membrana se vuelve insostenible.
La Hemólisis: La Ruptura Celular
Cuando la presión osmótica interna supera la resistencia de la membrana eritrocitaria, esta cede y se rompe. Este proceso se denomina hemólisis. La ruptura del eritrocito libera su contenido intracelular, incluyendo la hemoglobina, al medio circundante. En el caso de los eritrocitos, la hemólisis en agua destilada resulta en una solución rojiza debido a la presencia de hemoglobina libre.
La fragilidad osmótica de los eritrocitos es una medida de su resistencia a la ruptura en soluciones hipotónicas. Los eritrocitos normales muestran una resistencia osmótica característica, comenzando a hemolizarse en concentraciones de cloruro de sodio (NaCl) de aproximadamente 0.45% y completando la hemólisis en concentraciones alrededor de 0.32%.
Factores que Afectan la Fragilidad Osmótica
No todos los eritrocitos son idénticos en su resistencia a la lisis osmótica. Diversos factores pueden influir en su fragilidad:
- Edad del Eritrocito: Los eritrocitos más viejos tienden a ser más frágiles y a romperse más fácilmente en soluciones hipotónicas.
- Enfermedades Sanguíneas: Ciertas patologías, como la anemia drepanocítica (anemia de células falciformes), alteran la estructura y función de la membrana eritrocitaria. En la anemia drepanocítica, los eritrocitos afectados presentan una menor fragilidad osmótica en comparación con los eritrocitos normales, lo que puede parecer contradictorio pero se relaciona con una deshidratación celular previa y una mayor rigidez estructural en ciertas condiciones. Los eritrocitos drepanocíticos muestran resistencia globular mínima en soluciones de 0.36% de NaCl y máxima a 0.1% de NaCl, desplazando la curva de hemólisis hacia concentraciones más bajas de NaCl en comparación con los eritrocitos normales.
- Condiciones de Almacenamiento de la Muestra: La forma en que se recolectan, transportan y procesan las muestras de sangre puede inducir hemólisis. Factores como la punción traumática, el uso de agujas de pequeño calibre, el transporte inadecuado o la centrifugación a temperaturas incorrectas pueden dañar los eritrocitos y provocar su ruptura, incluso antes de realizar pruebas de laboratorio. La hemólisis es una causa frecuente de rechazo de muestras en laboratorios clínicos.

Implicaciones y Aplicaciones
El estudio de la ruptura de eritrocitos en agua destilada y en diferentes soluciones salinas tiene importantes implicaciones:
- Diagnóstico Médico: La prueba de fragilidad osmótica se utiliza para ayudar en el diagnóstico y la caracterización de anemias hemolíticas hereditarias, permitiendo evaluar la integridad de la membrana eritrocitaria.
- Investigación Biomédica: Permite investigar las propiedades de la membrana celular, el transporte de agua y solutos, y el efecto de diversas sustancias o condiciones sobre la estabilidad celular.
- Educación Científica: Sirve como un experimento clásico y accesible para ilustrar los principios fundamentales de la ósmosis, la difusión y la estructura celular.
Hemolisis
Prevención de la Hemólisis en Contextos Clínicos
En el ámbito de la medicina, la hemólisis en las muestras de sangre es un problema preanalítico significativo que puede llevar a resultados de laboratorio erróneos. La hemoglobina liberada durante la hemólisis puede interferir con diversas determinaciones bioquímicas. Para minimizar este efecto, se deben seguir protocolos estrictos durante la extracción, el transporte y el procesamiento de las muestras. Esto incluye el uso de dispositivos de punción adecuados, la correcta técnica de venopunción, el manejo cuidadoso de las muestras y la centrifugación en condiciones óptimas. La estandarización de estos procedimientos es crucial para garantizar la fiabilidad de los análisis clínicos.
En resumen, la ruptura de eritrocitos en agua destilada es un fenómeno observable que subraya la importancia de la homeostasis osmótica para la integridad celular. Este proceso, lejos de ser un mero evento de laboratorio, es un reflejo de los principios biológicos fundamentales que gobiernan la vida a nivel celular y tiene profundas implicaciones en el diagnóstico y la investigación médica.
tags: #ruptura #de #eritrocitos #agua #destilada